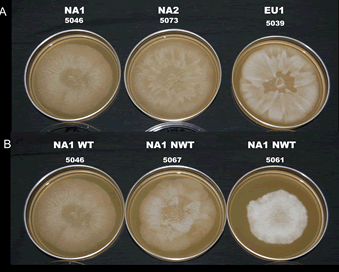
two rows of three petri dishes filled with an orange nutrient agar. in the center of each dish was placed a different sample of phytophthora. each sample has grown radially outward in a unique pattern, with some mycelia primarily growing within the agar and some growing entirely on top of it.

Phenotypic variation in Phytophthora ramorum: wild type vs non-wild type isolates
M. Elliott, Washington State University, Puyallup Research and Extension Center, Puyallup, WA, USA 98371; melliott2@wsu.edu ; G. Sumampong, S. F. Shamoun, E. Becker, Canadian Forest Service, Pacific Forestry Centre, Victoria, BC, Canada V8Z 1M5; A. Varga, D. James, S. Masri, Sidney Laboratory, Canadian Food Inspection Agency, Sidney, BC, Canada V8L 1H3; and N. J. Grünwald, Horticultural Crops Research Laboratory, USDA ARS, Corvallis, OR, USA 97330
In earlier studies, unusual culture morphology and behavior were noticed among some NA1 isolates of Phytophthora ramorum. This “non-wild type” behavior was not observed in our collection of isolates from the EU1 or NA2 lineages, even though the isolates had been in culture for a similar amount of time. It has been suggested that subculturing in vitro can cause culture instability and loss of virulence, and passage through the host can revive the isolate back to its original state. To study this, we compared four less virulent isolates (non-wild type; nwt) with four isolates of normal virulence (wild type; wt) in our culture collection. One objective of this study was to determine whether wt behavior could be restored to nwt isolates of P. ramorum by successive re-isolation from host material. Detached leaves of rhododendron “Cunningham’s White” were inoculated with each of the isolates, which were re-isolated and tested for pathogenic aggressiveness, growth rate at maximum, optimum, and minimum temperatures, and chlamydospore production in vitro.
In both wt and nwt groups, there were significant differences in lesion size on detached rhododendron leaves between the original culture and the first re-isolation. Successive re-isolations were not different from the original culture and the first re-isolation. After re-isolation from the host, nwt isolates were still less aggressive than wt isolates. Along with lower aggressiveness on rhododendron leaves, nwt isolates produced fewer chlamydospores in V8 agar than did wt isolates. There was no difference in growth rate between the original culture and the first re-isolation for most isolates. However, nwt isolates were found to be more sensitive to temperatures below 2°C and above 28°C. The optimum growth temperature was 20°C.
Our preliminary results show that non-wild type isolates were more variable than wild type isolates in all of the characters tested, and were generally lower in aggressiveness, chlamydospore production, and growth rate at all temperatures for both the original culture and when re-isolated from a host. The greater variability suggests that these isolates are unstable or that slightly deleterious mutation(s) have accumulated in accordance with Muller’s ratchet resulting in reduced fitness. Wild type isolates performed better than non-wild type isolates in all of the phenotypic characters examined. Why nwt survives and proliferates is still a mystery. To understand the cause of these phenotypic differences, the role of cytoplasmic elements and differences in mitochondrial and nuclear DNA are being examined.
in
Proceedings of the Sudden Oak Death Fourth Science Symposium (pdf) 2010
Susan J. Frankel, John T. Kliejunas, and Katharine M. Palmieri, tech. coords.
Gen. Tech. Rep. PSW-GTR-229. Albany, CA: U.S. Department of Agriculture, Forest Service, Pacific Southwest Research Station. 378 p
WSU Puyallup Research & Extension Center
2606 West Pioneer, Puyallup, WA, 98371-4998 USA
Last updated 9/24/2025